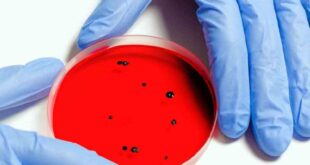

El mundo reportó 3.8 millones de casos de COVID-19 en la última semana, la cifra más baja desde mediados de noviembre El mundo reportó 3.8 millones de casos de COVID-19 en la última semana, la cifra más baja desde que a mediados de noviembre se detectaran los primeros casos de …
LEER MÁSOMS registra cerca de 230 casos probables de misteriosa hepatitis en niños
La mayoría de los casos se registran en Europa, sobre todo en el Reino Unido. La Organización Mundial de la Salud (OMS) sigue recibiendo decenas de informes sobre casos de una misteriosa hepatitis que afecta a los niños y ha registrado hasta ahora unos 230 casos en el mundo entero, …
LEER MÁSOMS detecta dos nuevas subvariantes de ómicron; analiza si son peligrosas
La OMS añadió la BA.4 y la BA.5, variantes hermanas de la original BA.1 de ómicron, a su lista de seguimiento La Organización Mundial de la Salud (OMS) dijo hoy, 11 de abril de 2022, que está analizando la peligrosidad de dos nuevas subvariantes de ómicron del COVID-19 para evaluar …
LEER MÁSCepa XE de ómicron puede ser la más contagiosa: OMS
Nuevas variantes de COVID emergen en China y aumenta una variante potencialmente más transmisible en el Reino Unido. El descubrimiento de nuevas variantes de covid que emergen en China y el aumento de una variante potencialmente más transmisible en el Reino Unido ha vuelto a poner de relieve el riesgo …
LEER MÁSMuertes por Covid 19 en el mundo caen a su cifra más baja en dos años: OMS
Desde el principio de la pandemia se han contabilizado al menos 470 millones de casos de COVID, con más de seis millones de muertes. El mundo registró la semana pasada una caída del 23% en el número de muertes por COVID-19 (32,959), lo que supone la cifra más baja desde …
LEER MÁSPandemia de Covid 19 está “lejos de haber terminado”, dice responsable de la OMS
La portavoz de la Organización Mundial de la Salud dijo que basa su información en un aumento de los casos en sus últimos datos semanales El fin de la pandemia de COVID-19 está muy lejos, dijo el viernes una portavoz de la Organización Mundial de la Salud, que basa su …
LEER MÁSOMS suspende evaluación de vacuna rusa contra COVID-19, Sputnik V, por invasión a Ucrania
La OMS considera que la situación en Rusia es ‘inestable’ debido al conflicto originado por la invasión a Ucrania La Organización Mundial de la Salud (OMS) anunció que postergará su evaluación de la vacuna rusa contra el COVID-19, Sputnik V, debido a “la situación inestable” por la invasión rusa a …
LEER MÁSLa OMS insta a destruir virus peligrosos en laboratorios de Ucrania
La OMS “recomendó encarecidamente al Ministerio de Sanidad ucraniano y a otras agencias responsables que destruya los patógenos muy peligrosos para impedir que se propaguen por accidente” La Organización Mundial de la Salud (OMS) instó “encarecidamente” a Ucrania a deshacerse de posibles “patógenos muy peligrosos” en sus laboratorios para evitar …
LEER MÁS‘Es demasiado pronto para declarar la victoria en batalla contra covid’: OMS
Tedros Ghebreyesus, director general de la Organización Mundial de la Salud, advirtió que con la alta transmisión del virus, ‘la amenaza de una nueva y más peligrosa variante sigue siendo real’ El director general de la Organización Mundial de la Salud (OMS), Tedros Adhanom Ghebreyesus, calificó de “alentador” el descenso …
LEER MÁSOMS da luz verde al molnupiravir, primer tratamiento oral contra Covid 19
La OMS recomienda su utilización en pacientes de COVID-19 que no hayan desarrollado formas graves de la enfermedad y que corran un muy alto riesgo de hospitalización La Organización Mundial de la Salud (OMS) anunció la inclusión del antiviral molnupiravir en su lista de tratamientos recomendados contra la COVID-19, por …
LEER MÁS Yucatán al Instante Noticias al Instante
Yucatán al Instante Noticias al Instante